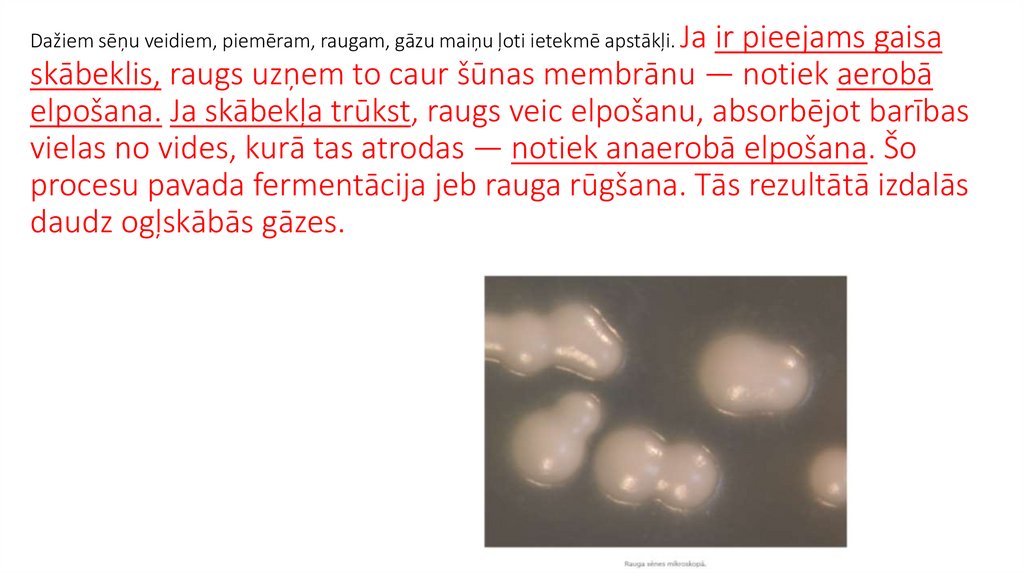

Похожие презентации:
Augu un sēņu elpošana
1.
2. Augu un sēņu elpošana
Uzzināsi, kā augi elpo un kā tie elpošanai izmanto skābekli, ko paši saražojuši.Uzzināsi, kā elpo sēnes.
Uzzināsi, kā augi elpo un ka tie elpošanai izmanto skābekli, ko paši saražojuši.
Uzzināsi, kā elpo sēnes. Veicot pētniecisko darbu un laboratorijas darbu,
novērosi kā augu un sēņu elpošanu ietekmē dažādi faktori. Reģistrēsi datus,
izmantojot IT.
Uzstadit CO2sensoru
3. j.v.
• gāzu maiņa - газообмен• šūnu elpošana - клеточное дыхание
• Fotosintēze - Фотосинтез
• Atvārsnītes - устьице
• Enerģija - Энергия
• ogļskābā gāze - углекислый газ
• Skābeklis - Кислород
• Ūdens - Вода
• organiskās vielas - органические вещества
4. Augu elpošana
• Augu šūnām tāpat kā visu dzīvo organismu šūnām irvajadzīga enerģija, tāpēc tās elpo un uzņem skābekli.
Augiem nav speciālu elpošanas orgānu, taču skābeklis
sasniedz katru šūnu. Kā tas notiek?
• Augi elpo caur ķermeņa virsmu,
kuru klāj epiderma. Caur atvārsnītēm
epidermā notiek gāzu maiņa un ūdens iztvaikošana. Ja
atvārsnītes ir atvērušās, caur tām ieplūst
skābeklis, bet no tām izplūst ogļskābā
gāze. Elpo visi orgāni — lapas, saknes, stumbrs, ziedi,
augļi un sēklas. Augi elpo nepārtraukti — dienā un naktī,
gaismā un tumsā, jo tikai šādi šūnas spēj saražot
pietiekami daudz enerģijas. Augu šūnu
mitohondrijos notiek šūnu elpošana — līdzīgs
process kā dzīvnieku šūnās.
5. Atšķirībā no dzīvniekiem, kas barojas, ēdot zāli vai dodoties medībās, augi barības vielas (organiskās vielas) iegūst
fotosintezējot. Fotosintēze norisinās tikai dienas laikā (gaismā), un tās procesā rodas arī skābeklis. Daļu skābekļa šūnu elpošanāpatērē paši augi, bet liela daļa caur atvārsnītēm tiek izvadīta atmosfērā. To elpošanai patērē arī citi dzīvie organismi.
Naktī (tumsā) fotosintēze nenotiek un augi elpošanai izmanto tikai atmosfēras skābekli. Skābekļa rezerves atmosfērā neizsīkst,
jo dienas laikā fotosintezējot, augi izvada atmosfērā daudz vairāk skābekļa nekā paši patērē kopā gan dienā, gan naktī.
Gaismā augi gan
elpo, gan fotosintezē,
tumsā — tikai elpo.
6. Diskusija Aplūkojiet attēlus un atbildiet uz jautājumu! Izspried, kurās situācijās (dzelzceļa stacijā, pilsētvidē, guļamistabā)
augi ir ļoti nepieciešami,bet, kurās bez tiem
labāk iztikt! Argumentē
viedokli!
7. Augu elpošanas intensitāte mainās atkarībā no apstākļiem un dzīvības procesiem. Jaunās auga daļas, piemēram, pumpuri, dīgstošas
sēklas vai tikko izplaukušas lapas, elpo intensīvāk, jo vajadzīgaenerģija augšanai, jaunu šūnu un audu attīstībai. Novietojot tās siltumā, šūnas sāk elpot
aktīvāk, tērējot sēklās uzkrāto, un sēklas uzdīgst ātrāk. Šūnu elpošanu var arī mazināt. Lai dārzeņi
nezaudētu uzturvērtību, tos uzglabā vēsumā — pagrabā vai ledusskapī, tādējādi samazinot organisko vielu patēriņu
šūnu elpošanai.
Kāpēc dārzeņus uzglabā pagrabā?
8. Domā, pēti, secini! Zemnieks novāca burkānu ražu, pilnās kastes nosvēra un ievietoja pagrabā. Pavasarī, pirms vešanas uz tirgu,
nosvēra atkārtoti un secināja, ka kastes joprojām ir pilnas ar burkāniem, bet tās kļuvušas vieglākas.Izskaidro, kas 6 mēnešu laikā noticis ar burkāniem! Iesaki zemniekam, ko darīt, lai
ražas zudumi būtu mazāki!
9. Sēņu elpošana
• Sēnes ir gan vienšūnas, gan daudzšūnu organismi, kuribarojas ar gatavām organiskām vielām un elpošanai
izmanto skābekli. Sēnēm nav hloroplastu, kas ļautu
efektīvi izmantot saules gaismu, lai ražotu barības vielas. Tā vietā
sēnes visas nepieciešamās vielas iegūst no apkārtējās vides.
• Sēnes lielākoties aug zemē, bez saules gaismas
un atmosfēras gaisa. Tomēr, līdzīgi pārējiem dzīvajiem
organismiem, tās elpo. Augsne sastāv no dažādām minerālvielu un
organisko vielu daļiņām, kā arī ūdens. Starp šīm daļiņām ir nelielas
gaisa spraugas. Šis gaiss, tāpat kā virszemē esošais gaiss, satur
skābekli, kas tiks izmantots šūnu elpošanai un enerģijas ieguvei.
• Ja no zemes noņemtu virskārtu, kļūtu redzams micēlijs — ļoti
daudz sīku sakņu tīklam līdzīgu pavedienu, kuri veido lielāko daļu
sēņu ķermeņa. Šīs struktūras sauc par hifām, un tās var būt tik
sīkas, ka ir grūti atšķiramas no pašas augsnes. Hifas var ieaugt
tik sīkās spraugās, kurās augu saknes netiek, un var
uzņemt skābekli no mikroskopiskajām augsnes
spraugām. Savukārt virs zemes esošajiem sēnes
augļķermeņiem gāzu uzņemšana notiek no atmosfēras.
Sēnes micēlijs un jaunie augļķermeņi
10. Diskusija Aplūkojiet attēlu un atbildiet uz jautājumu! Kāpēc, pārlieku palielinoties mitrumam kādā vietā, sēnes no tās atkāpjas
vai pārstāj augt? Kāda loma tajā ir elpošanai?11. Dažiem sēņu veidiem, piemēram, raugam, gāzu maiņu ļoti ietekmē apstākļi. Ja ir pieejams gaisa skābeklis, raugs uzņem to caur
šūnas membrānu — notiek aerobāelpošana. Ja skābekļa trūkst, raugs veic elpošanu, absorbējot barības
vielas no vides, kurā tas atrodas — notiek anaerobā elpošana. Šo
procesu pavada fermentācija jeb rauga rūgšana. Tās rezultātā izdalās
daudz ogļskābās gāzes.
12. Maizes raugs ir vienšūnas sēne, kas barojas ar gatavām organiskām vielām — cukuru. Šūnas ir mikroskopiski mazas, vairojas
Maizes raugs ir vienšūnas sēne, kas barojas ar gatavām organiskām vielām — cukuru. Šūnas irmikroskopiski mazas, vairojas pumpurojoties.
Kāpēc rauga sēni izmanto mīklas pagatavošanas procesā?
• Mīkla rūgst, jo rauga šūnas noārda pievienotās organiskās vielas (cukuru) un iegūst enerģiju saviem dzīvības
procesiem. Mīklas gatavošanas procesā šo sēni var viegli pievienot un iemaisīt. Raugs elpojot izdala ogļskābo
gāzi, mīklu padarot irdenu, bet izcepto maizi, pīrāgus vai pankūkas — čaganas un garšīgas!
• Rauga elpošanu jeb mīklas rūgšanu ietekmē temperatūra, cukuru daudzums, mīklas maisīšanas un mīcīšanas
intensitāte, rauga veids (sausais vai mitrais). Jo intensīvāka rauga elpošana, jo vairāk izdalās ogļskābā gāze un
izcilā mīklu, padarot to gaisīgu.
13. Domā, pēti, secini! Kāpēc mīkla jāmīca? Kas notiks, ja saimniece to būs aizmirsusi izdarīt? Kāpēc pēc mīklas izmīcīšanas ir
jāpaiet zināmam laikam, pirms to izmanto cepšanai?Ko šajā laikā dara rauga sēne?
14. Ieraksti ciparu! Raugs elpojot saražo ogļskābo gāzi. Attēlā redzama diagramma, kurā ar CO2 sensoru reģistrēta rauga elpošanas
intensitāte 5 min. Cik reizes irapmaisīts rauga šķīdums?
Diemžēl nepareizi! 2xJa maisa rauga šķīdumu, tad palielinās skābekļa
daudzums tajā, attiecīgi šūnām elpojot strauji pieaug ogļskābās gāzes
koncentrācija. Šo likumsakarību izmanto mīklas raudzēšanas
tehnoloģijā.
3
15. Atzīmē pareizās atbildes! Kā augi spēj uzņemt skābekli?
a)caur ķermeņa virsmub)tikai caur lapu virsmu
c) Augi skābekli neuzņem, jo tiem vajadzīga ogļskābā gāze.
d)caur atvārsnītēm epidermā
2xAugi elpo caur visu ķermeņa virsmu, kuru klāj epiderma.
14
16. Atzīmē pareizo atbildi! Kas notiek lapu atvārsnītē elpošanas procesa laikā?
a) Tiek uzņemts skābeklis (B) un izdalīta ogļskābā gāze (A).b) Tiek uzņemta ogļskābā gāze (B) un izdalīts skābeklis (A).
c) Tiek uzņemts skābeklis (B), izdalīts ūdens (A).
d) Tiek uzņemts skābeklis (B) un izdalīta enerģija (A).
17. Atzīmē pareizo atbildi! Kāds augu vielmaiņas process nodrošina ne tikai pašus augus, bet arī citus organismus ar skābekli?
a)elpošanab)fotosintēze
1xAtšķirībā no dzīvniekiem, kas barojas, ēdot zāli vai dodoties medībās, augi fotosintēzes procesā barības vielas (organiskās vielas) saražo paši. Šajā procesā izdalīto skābekli elpošanai patērē visi dzīvie organismi.
18. Atzīmē pareizās atbildes! Kādos apstākļos notiek elpošanas process augu šūnās?
a)dienāb)naktī
c) aukstumā
d)vienīgi gaismā
e)tikai tumsā
f) tumsā
g)mākslīgajā apgaismojumā
h)siltumā
Diemžēl nepareizi! 3x Aukstumā augu dzīvības procesi apstājas vai notiek ļoti lēni.
19. Atzīmē pareizo atbildi! Kas kopīgs attēlā redzamo organismu elpošanas procesam?
a) Spēj uzņemt atmosfēras skābekli .b) Tiem vajadzīgs ūdens.
c) Elpošanas procesu nodrošina elpošanas orgāni.
d) Elpojot patērē organiskās vielas un izdala
skābekli.
20. Atzīmē pareizo atbildi! Kurš rauga sēnes dzīvības process visātrāk palielina mīklas apjomu?
a) Barošanāsb) elpošana, vairošanās
c) Vairošanās
d) ūdens uzņemšana šūnās
3xVairošanās rezultātā nerodas ogļskābā gāze
1x Diemžēl nepareizi! Barošanās rezultātā nerodas ogļskābā gāze.
21. Atzīmē pareizās atbildes! Kāpēc dažādus augļus un dārzeņus ir ieteicams uzglabāt vēsā vietā?
a) Lai apturētu fotosintēzes procesu un skābekļaražošanu.
b) Vēsumā tiek apstādināta augšana.
c) Zemā temperatūrā palēninās augu šūnu
vielmaiņa un elpošana, tāpēc vajag mazāk
enerģijas.
d) Vēsumā mazāk noārdās organiskās vielas,
saglabājas produktu uzturvērtība.
22. Atzīmē pareizo atbildi! Kurā attēlā redzamie graudi elpo intensīvāk? Izvērtē, kurš apgalvojums raksturo atšķirības?
a) Sausi graudi (B) elpo intensīvāk, jo vajadzīgaenerģija ilgam uzglabāšanās laikam.
b) Elpošanas intensitāte neatšķiras, jo visas sēklas
elpo.
c) Dīgstoši graudi (A) elpo intensīvāk, jo vajadzīga
enerģija jaunu šūnu un audu attīstībai.
d) Dīgstošie graudi (A) patērē mazāk skābekļa
nekā sausie, jo tie jau ir izdīguši.
23.
Nosauc atbildi! Kurā auga, dzīvnieka un sēnes šūnas organoīdā notiekšūnas elpošana un enerģijas ražošana?
Augu šūnu elpošanas process notiek līdzīgi kā cilvēku šūnās.
24.
Pasaki atbildi!• Vienšūnas sēne, kas iegūst enerģiju, izmantojot cukuru un skābekli.

Биология
Биология








